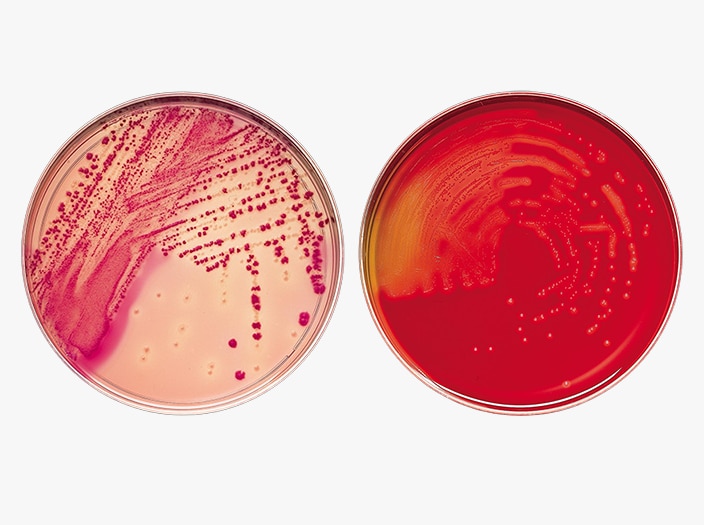
BD BBL prepared plated media Petri-style dishes
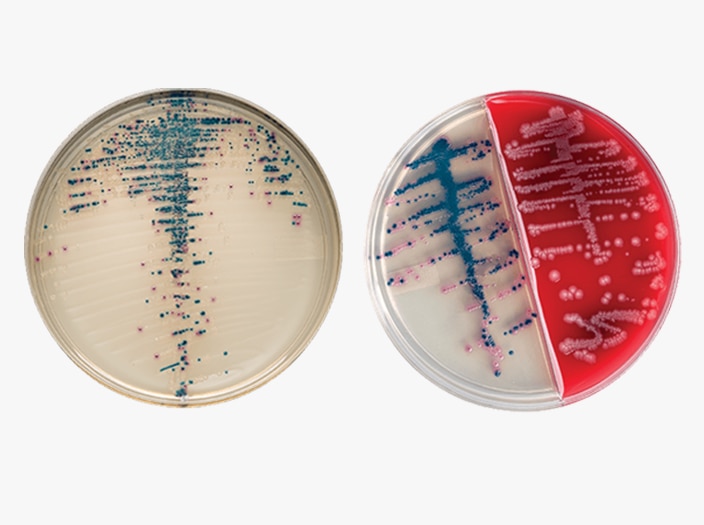
BD BBL CHROMagar prepared plated media Petri-style dishes

Advanced Diagnostics
Help advance care for patients throughout their diagnostic journey, while also addressing your testing needs

BD Diagnostic Solutions is Now Waters Advanced Diagnostics
BD Diagnostic Solutions and Biosciences have combined with Waters Corporation to create a life sciences and diagnostics leader driven by innovation and a relentless commitment to our customers.
As we begin our new journey as part of Waters, there will be no immediate changes in how we serve you. The way you order your products and services and how you process payment for them will not change. Your points of contact for sales, customer service, technical service and support or clinical services will remain the same.
Your diagnostic challenges are interconnected. Your solution should be too.
98% of hospital inpatients undergo some form of diagnostic testing.1 Diagnostic tests for blood culture, blood chemistry and urine affect nearly every patient in your facility. These tests are critical to determining the next step in their treatment. And while ensuring patient care is your primary priority, you may also face other challenges such as complex tests, suboptimal workflows, preanalytical errors and staffing shortages.
These concerns are not siloed – they impact each other, and your patients. What if you could integrate your facility’s diagnostic pathway, with solutions at each step working together?
Watch the video to explore how we are delivering innovations that begin and end with patients:
Enabling you to advance patient care at each step
From collecting specimens to reporting results, the diagnostic pathway has multiple points, each with the potential to optimize efficiencies and advance the quality of patient care. We offers a comprehensive portfolio of diagnostic solutions designed to help your facility elevate the patient experience and position your lab as a vital resource, rather than a necessary cost center.

BD Veritor™ Plus System
Integrated, digitally connected testing that removes any guesswork—by interpreting and providing rapid, clear results for SARS-CoV-2, Flu A+B, SARS-CoV-2 & Flu A+B,* Group A Strep, and RSV—so you can move forward with confidence.

BD BACTEC™ Blood Culture Media
Decrease time to detection during the analytical phase with a full spectrum of blood culture media solutions. A full line of blood culture media developed specifically for the detection of aerobes, anaerobes, yeast, fungi and mycobacteria to help improve time to detect and organism recovery2 from both adult and pediatric patients.

Cervical Cancer Screening
Progress starts here and now. As a single source, our advanced molecular and cytology testing solutions offer flexibility to accommodate preferred testing approaches from screening to triage. Together, we can save more lives by vaccinating, screening and treating HPV early.

BD Universal Viral Transport System
The BD universal viral transport (UVT) system is designed to transport viruses, chlamydiae, mycoplasmas and urea plasmas at room temperature. It is one of the only systems that may be stored and transported at 2°C to 25°C—all in one formulation.

BD ESwab® Collection and Transport System
The system helps collect clinical specimens containing aerobic, anaerobic and fastidious bacteria from the collection site, and transport them to the testing laboratory. In the lab, BD ESwab® specimens are processed using standard clinical lab operating procedures for bacterial culture. The unique design of the flocked swab ensures optimal elution of the specimen into the transport medium.

BD Kiestra™
BD Kiestra™ laboratory automation solutions are uniquely positioned to offer standardized and scalable solutions for inoculation, incubation, plate imaging and reading and follow-up testing.
BD Kiestra™ solutions help prepare laboratories to meet these changing demands and achieve efficient, timely and cost-effective clinical bacteriological testing.
BD BBL™ Prepared Plated Media
BD BBL™ prepared plated media enable the isolation of microorganisms from samples or specimens. Ready for immediate use, they are routinely available in several types of Petri-style dishes, containing a variety of media.
BD BBL™ CHROMagar™ Plated Media
The BD BBL™ CHROMagar™ family uses a chromogen mix that releases colored compounds after degradation by specific microbial enzymes. You can visually detect the bacteria by a distinct color change within the colony, so you can easily differentiate species with minimal confirmatory tests.

BD BACTEC™ FX Blood Culture System
It has advanced fluorescence detection technology, exceptional media performance and instrument reliability—adding vial-activated workflow, advanced ergonomics, blood culture observation and customer-focused data management. The easy-to-use workflow comes in a compact, modular design, which can be adapted to multiple space- and time-saving configurations for your laboratory staff.

BD MAX™
The BD MAX™ system offers you an efficient path to improved clinical outcomes by combining and automating extraction and thermocycling into a single platform capable of running both FDA-cleared and open system assays. Flexibility and standardization allow you to address the breadth of your testing needs.

BD COR™ System
Delivering efficiency, flexibility, and performance to meet your laboratories' evolving molecular diagnostic needs. The BD COR™ System uses multiplex PCR assay design and requires less than 1 hour of daily hands-on time for the full BD COR™ system workflow and only 2 interactions.

BD Phoenix™ Automated ID/AST Testing System
The BD Phoenix™ M50 instrument provides clinicians with accurate and timely identification and susceptibility results to help guide their therapy and patient management decisions. BD Phoenix™ panels provide accurate, rapid identification and susceptibility results for most clinically significant aerobic and facultative anaerobic Gram-negative and Gram-positive bacteria, as well as identification of yeast and yeast-like organisms.

BD Bloodstream Infection (BSI)
Take an integrated approach to BSI testing. A bloodstream infection (BSI) can lead to a dysregulated immune response if untreated. BSI’s can lead to potentially life-threatening conditions, including sepsis. To make substantial improvements to BSI testing, consider the entire diagnostic pathway – from blood culture collection to result.

BD Synapsys™ Informatics Solution
BD Synapsys™ solution enables laboratories to address challenges and improve laboratory outcomes. It enables labs to maximize performance using enhanced microbiology diagnostic informatics through a single, advanced platform with an intuitive, personalized user interface.

BD EpiCenter™ Microbiology Data Management
The BD EpiCenter™ microbiology data management system provides advanced data management for BD microbiology systems. It helps integrate these multiple platforms, facilitate improved workflow, analyze data and generate reports, including those used for epidemiological tracking.
4 reasons to partner with us for Advanced Diagnostics
to understand your current challenges and unmet needs aimed at revealing the most effective ways to address clinical quality & workflow impact using BD solutions
to increase proficiency and minimize the learning curve
to address your queries and testing needs
to streamline testing workflows at your facility
Our comprehensive portfolio is backed by our leading-edge science, innovation technology, proven expertise and support services, enabling you to address your ongoing clinical and operational needs.
Let’s advance diagnostic value and impact in your facility.
Get in touch with a sales representative
Diagnostic tests classify infections and guide therapies, enabling clinicians to implement effective antimicrobial interventions
-

Advanced Diagnostics aims to optimize patient care pathways through essential tests crucial for making treatment decisions.
-

Advanced Diagnostics are designed to support your ability to minimize the effort to get accurate diagnostic results and help keep your lab ahead of the curve.
-

Advanced Diagnostics aims to equip pharmacists with integrated point-of-care solutions, enhancing convenience and diagnostic confidence.
References
References:
- Ngo A, Gandhi P, Miller WG. Frequency that laboratory tests influence medical decisions. J ApplLab Med. 2017;1(4):410-414.
- Hawkins R. Managing the pre- and post-analytical phases of the total testing process. Ann Lab Med. 2012;32:5-16.
Notes:
*In the USA, the BD Veritor™ System for Rapid Detection of SARS-CoV-2 & Flu A+B has not been FDA cleared or approved but has been authorized by the FDA under an Emergency Use Authorization for use by authorized laboratories; use by laboratories certified under the CLIA, 42 U.S.C. §263a, that meet requirements to perform moderate, high, or waived complexity tests. The product is authorized for use at the Point of Care (POC), i.e., in patient care settings operating under a CLIA Certificate of Waiver, Certificate of Compliance, or Certificate of Accreditation.
This product has been authorized only for the detection of proteins from SARS-CoV-2, influenza A and influenza B, not for any other viruses or pathogens; and, in the USA, the emergency use of this product is only authorized for the duration of the declaration that circumstances exist justifying the authorization of emergency use of in vitro diagnostics for detection and/or diagnosis of COVID 19 under Section 564(b)(1) of the Federal Food, Drug and Cosmetic Act, 21 U.S.C. §360bbb-3(b)(1), unless the declaration is terminated or authorization is revoked sooner.
Disclaimer:
This business has been acquired by Waters Corporation (“Waters”). For products referenced on this page, the legal manufacturer remains Becton, Dickinson and Company or one of its affiliates or subsidiaries (“BD”) until all required regulatory transfers are completed. During this interim period, BD maintains full responsibility for all regulatory obligations of the legal manufacturer. Product information provided here is supplied under the regulatory authority of BD. To learn more about the relationship between Waters and BD during this transition period, please see our detailed summary waters.com/bdtransaction.
